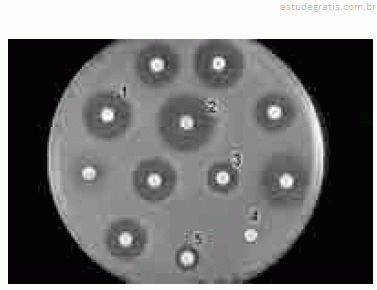

Questão
Q240048
Prova: Concurso Prefeitura de Limeira - SP - Técnico Área Patologia Clínica - Centro de Seleção e de Promoção de Eventos UnB (CESPE) do ano 2007
•
Prefeitura de Limeira - SP
Considerando a figura de ensaio biológico apresentada aci...
Considerando a figura de ensaio biológico apresentada acima, julgue os itens a seguir.
Na figura acima, a bactéria em estudo é resistente ao antimicrobiano empregado na concentração representada pelo disco indicado pelo número 2.
Comentários
Faça login para participar da discussão.
Cadastre-se Gratuitamente
Carregando comentários...